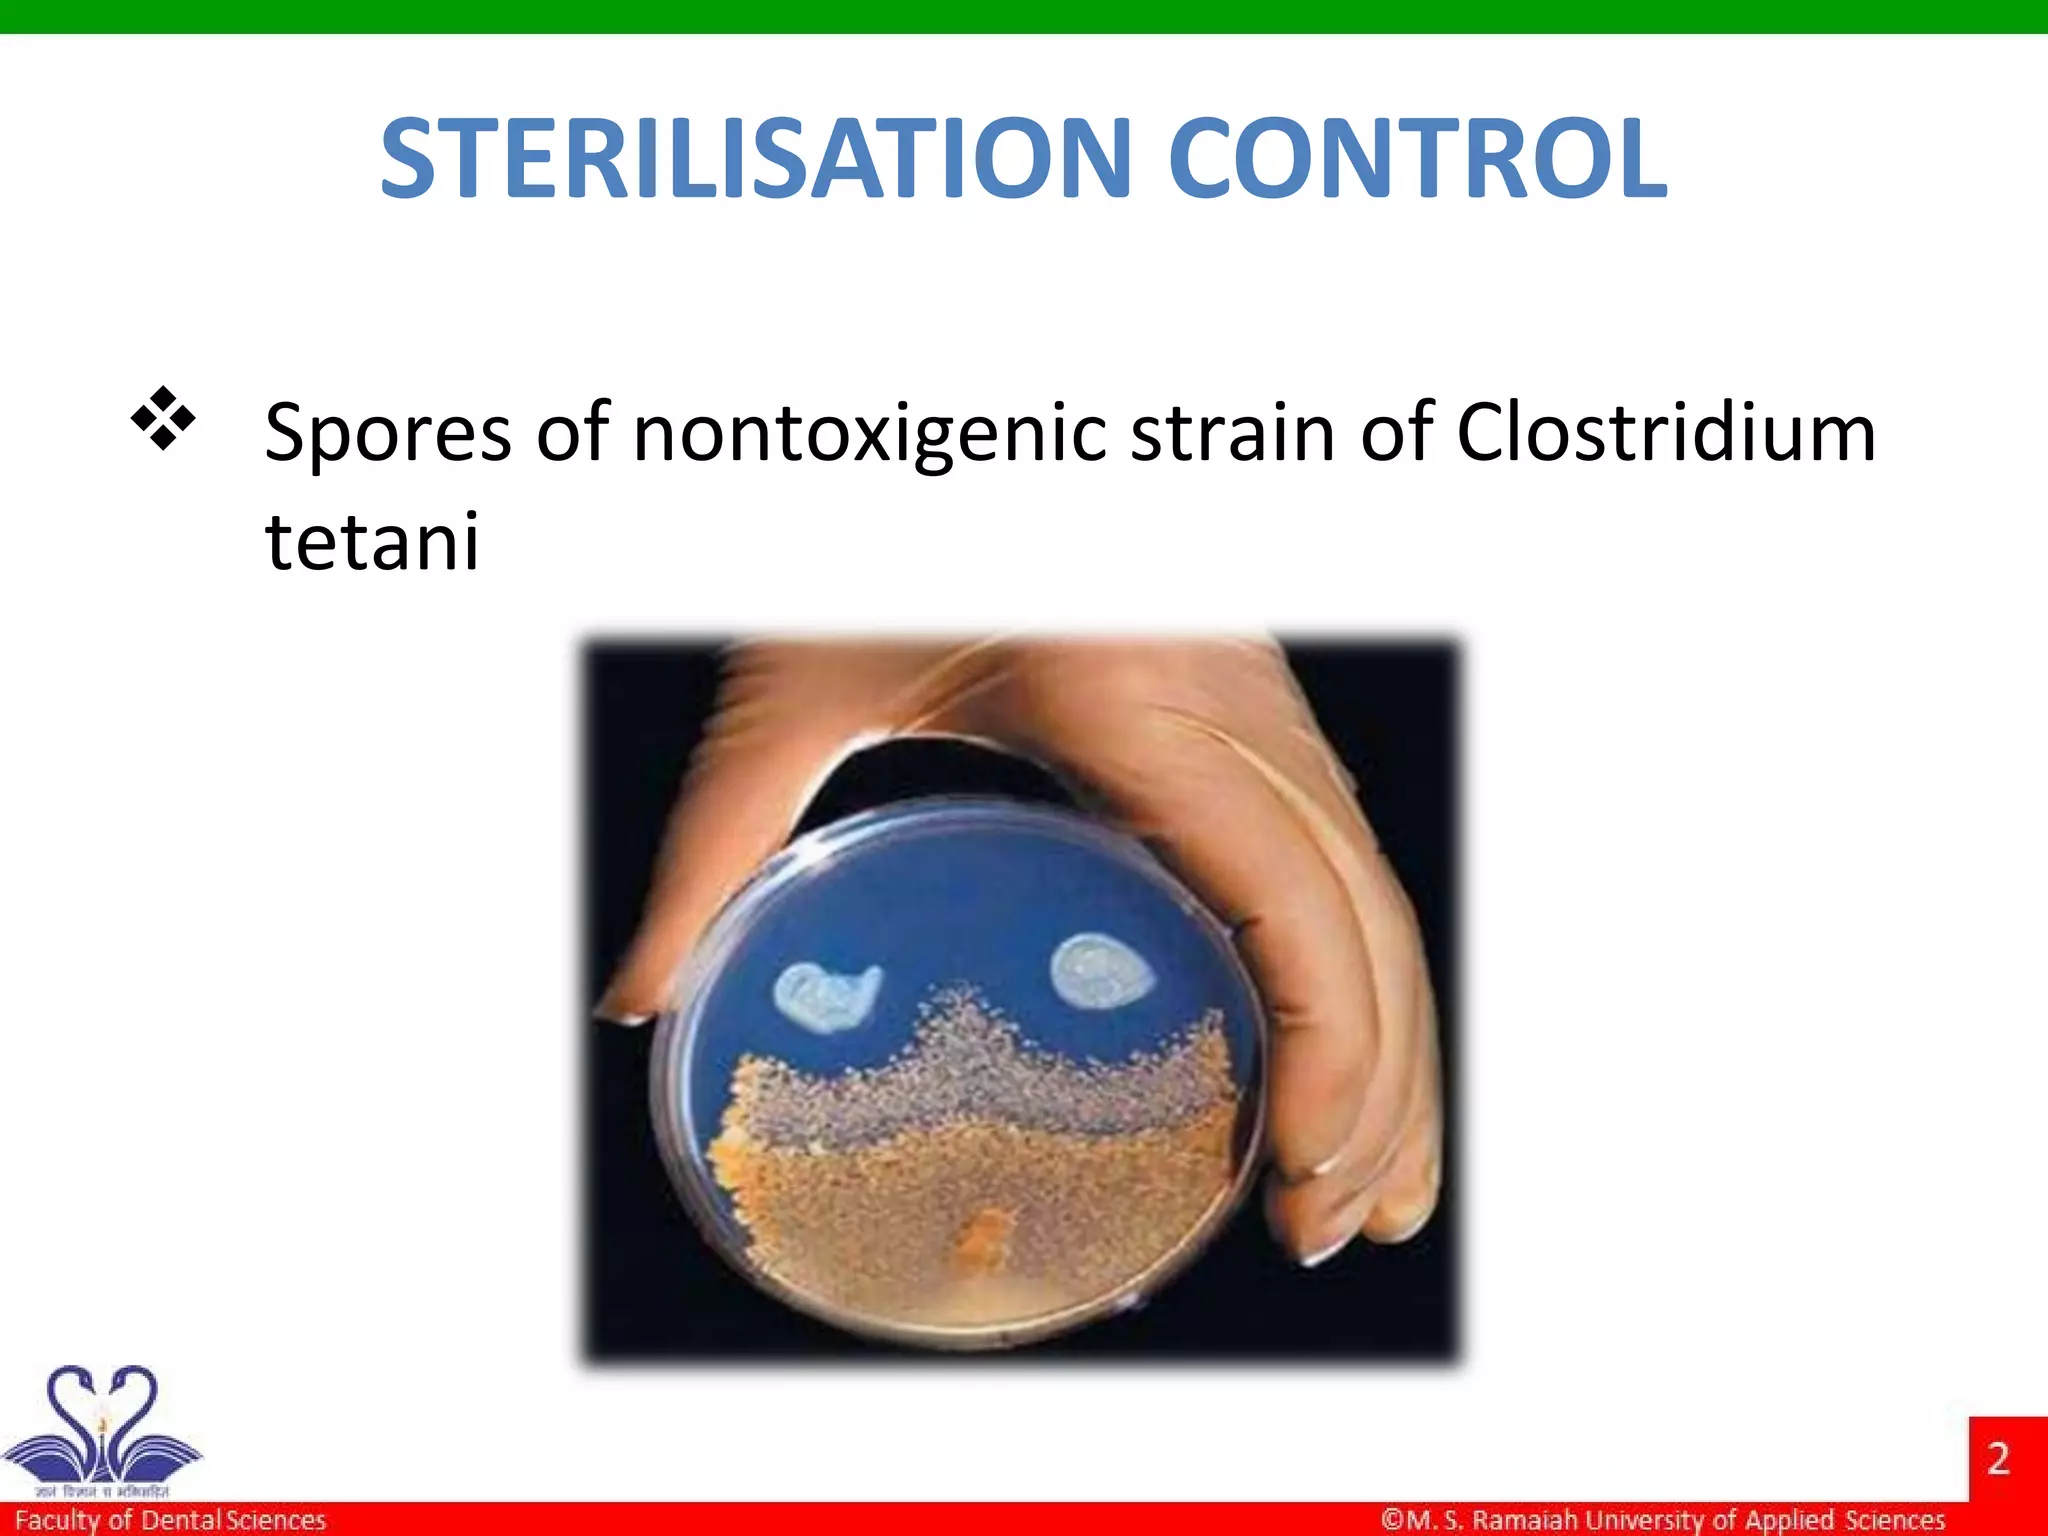
STERILISATION CONTROL
 Spores of nontoxigenic strain of Clostridium
tetani

The document discusses physical methods of sterilization, outlining the necessity of eliminating microorganisms to prevent contamination and infection. It details various sterilization techniques, including dry and moist heat, filtration, and radiation, emphasizing their principles, advantages, and limitations. Key factors such as time, temperature, and the characteristics of the microorganisms are critical for effective sterilization.